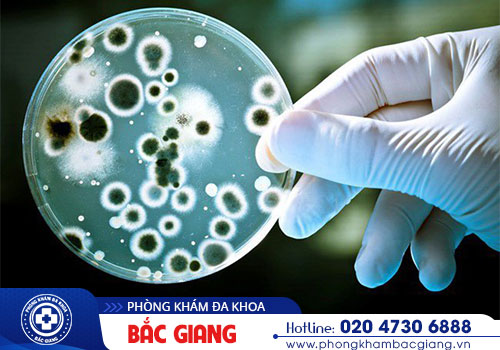

- Bệnh lậu là một trong những bệnh xã hội phổ biến do vi khuẩn song cầu khuẩn lậu có tên là Neisseria Gonorrhoeae gây nên. Thông thường, vi khuẩn lậu này thích sống ở những nơi ẩm ướt, kín đáo và ấm áp.
Các Bác sĩ chúng tôi đều đang Online
Hãy bấm CHAT NGAY để được tư vấn nếu bạn cần giúp đỡ
Hãy bấm CHAT NGAY để được tư vấn nếu bạn cần giúp đỡ
Lưu ý: 10 lần tìm kiếm trên Google không bằng 1 lần chat với Bác sĩ
Bạn có thể để lại thông tin để yêu cần giúp đỡ
(1).jpg)
Tự mua thuốc điều trị bệnh lậu được không?
Với tâm lý mặc cảm, xấu hổ nên khi biết mình mắc bệnh lậu nhiều người thường tìm cách chữa trị tại nhà mà không ...
.jpg)
Phương pháp điều trị bệnh lậu hiệu quả hiện nay
Những biến chứng bệnh lậu không chỉ ảnh hưởng đến sức khỏe, tâm lý người bệnh mà còn có nguy cơ lây lan rộng ra ...
.jpg)
Bệnh lậu có chữa được không?
Bệnh lậu là một trong những bệnh xã hội nguy hiểm lây truyền qua đường tình dục không an toàn. Bệnh có thể gây ra các ...
(1).jpg)
Bệnh lậu ở nữ giới và những biến chứng nguy hiểm
Bệnh lậu từ lâu được biết đến như một căn bệnh xã hội gây ra nhiều biến chứng nguy hiểm. Đặc biệt ở nữ giới ...

Xét nghiệm bệnh lậu ở đâu uy tín?
Để phát hiện bệnh lậu sớm và kịp thời can thiệp điều trị bệnh thì sau khi phơi nhiễm bệnh, hoặc khi có những dấu ...
Xét nghiệm bệnh lậu gồm các xét nghiệm nào?
Bệnh lậu không chỉ gây ra những ảnh hưởng tiêu cực tới sức khỏe của bệnh nhân mà còn làm suy giảm chất lượng cuộc ...

Xét nghiệm bệnh lậu có đắt không?
Bệnh lậu là căn bệnh xã hội nguy hiểm, có tốc độ lây lan nhanh chóng. Nếu không phát hiện và can thiệp điều trị bệnh ...

Xét nghiệm lậu sớm có lợi ích gì? Khi nào cần thực hiện xét nghiệm?
Lậu là một trong các căn bệnh tình dục nguy hiểm, là mối lo của toàn xã hội. Việc xét nghiệm lậu giúp phát hiện bệnh ...

